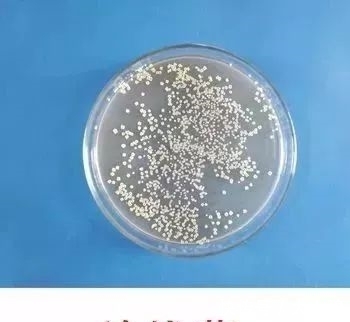
线菌|男子手摸一物后住院7次，这种古玩不要随便乱摸，不小心会丢命!
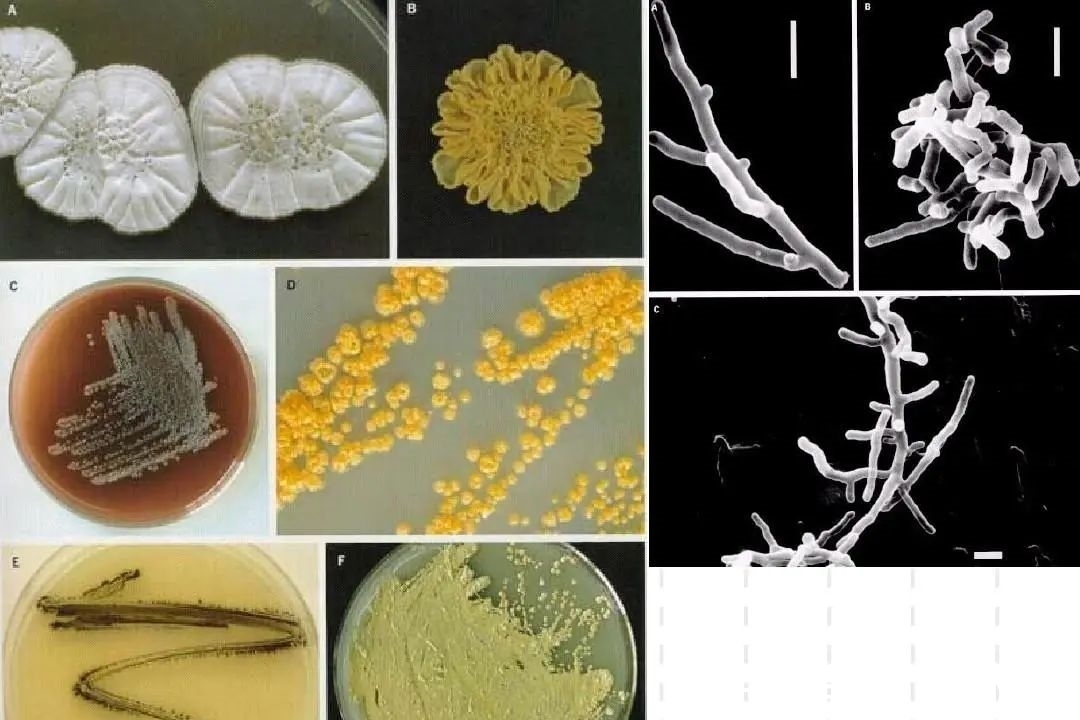
线菌|男子手摸一物后住院7次，这种古玩不要随便乱摸，不小心会丢命!

线菌|男子手摸一物后住院7次,这种古玩不要随便乱摸,不小心会丢命!
玩古玩的人,
应该没有人不喜欢逛古玩市场吧,
但是逛归逛,不要手多多,随处摸
要是摸到不该摸的,
生命都危险。
可不是胡言乱说,
这可有事实为证的。

文章插图
圈内有位老铁就深受其害,
这件事当时在圈内很多人都应该听闻过,
深圳老李平时酷爱古玩,
有事没事就爱泡在古玩市场,
甚至经常随朋友去外地鉴赏出土古玩。
然而最近一段时间,
老李身体突然变差了,
陆续出现咳嗽、发热、胸痛等症状,
老李一看自己这样不对劲,
赶紧去医院,检查过后医生说肺部感染
但感染源没查出来,
病情反复老李竟住院7次。
直到第八次,
医生了解到老李有玩古玩的习惯,
感染的原因很有可能是接触了
刚出土的古玩。
在触摸刚出土的古玩时,
不慎吸入了文物上存在的放线菌,
从而导致的肺部感染。
文章插图
你们试想,刚出土的古玩,
在地底下埋了不知道几十、几百年
埋葬这么长时间,
没有细菌存在怎么可能???
而放线菌在接触时会通过呼吸道吸入,
就这样子老李肺部被感染了。

文章插图
一个小小的放线菌,竟有这么大的威力?
放线菌,
广泛存在于土壤和动物的微生物群中,
部分是可和人体共生的有益菌类,
也有些是有害的。
它并没有什么明显的菌落特征,
容易跟其他病菌混合感染,
总之是一种很难检测出来的细菌,
危害性很高。
文章插图
其实很多对出土古玩有兴趣的人,
都应该注意下这个问题,
放线菌喜欢在含水量较低、
有机物丰富、微碱性的土壤中生长,
因此一些刚出土文物上,
非常容易带有大量的放线菌。

文章插图
以前常说,
不要佩戴来历不明的玉器,
否则容易招致厄运,
这不是没有根据的
因为对于一些真正的出土古玩来说,
它大多都是殉葬物品,
埋葬时间比较长
谁知道以前发生啥事,是好是坏
如果不慎收藏放到家中,
很容易破坏风水,伤到自身。

文章插图
【 线菌|男子手摸一物后住院7次,这种古玩不要随便乱摸,不小心会丢命!】其次,先不说这些类似鬼神论的事情
就上面提到的,出土古玩细菌多啊
你去看出土文物时,
是不是会闻到土里的泥腥味
那个其实就是放线菌代谢产物的气味了。
而泥土与古玩可以说是
合二为一埋在土里,
出土物件表面自然而然也覆盖上细菌。
万一你拿在手上的出土古玩是玉塞
古代用来塞肛门
又或者玉琀,古代殉葬是放在嘴巴的,
那得多少细菌啊!
而古玩市场也不会特意给你买的古玩消毒
人来人往,摸来摸去的,
皮肤很容易接触到细菌,
就好比我们出门回家必须洗手一样道理,
因为出门在外会皮肤会沾到细菌。

文章插图
玉塞▲
所以你平时也特别爱玩古玩
特别是出土的,
- 小林|男子一晚呼吸暂停176次?睡觉打鼾并非好事,背后或与这3件事有关
- 杭州男子总是“想女友”,竟是因为大脑……
- 男子|一斤白酒+12颗头孢,男子边淌汗边拔针:我没事,不用治!
- 甲亢|男子深夜突发心梗,险些离世!所有的突如其来,都是蓄谋已久。
- 硬度|厦门男子肠胃不适,喝了段时间猪肚汤,结果更严重了!送医检查竟是……
- 杭州男子总是出现“愣神”,竟是因为大脑……
- 男子|气到中毒?男子与女友吵架,吵到四肢僵硬倒地、双手痉挛、呼吸困难…...
- 男子1斤白酒+12粒头孢,没有发生双硫仑样反应,医生大惑不解
- 小林|男子抱怨天天睡醒“跟没睡一样”…医生:警惕,严重可猝死!
- 浙大一院|男子反复肠梗阻20年,一查原来是“双肠人”,肠子长期黏连结出个“茧”
